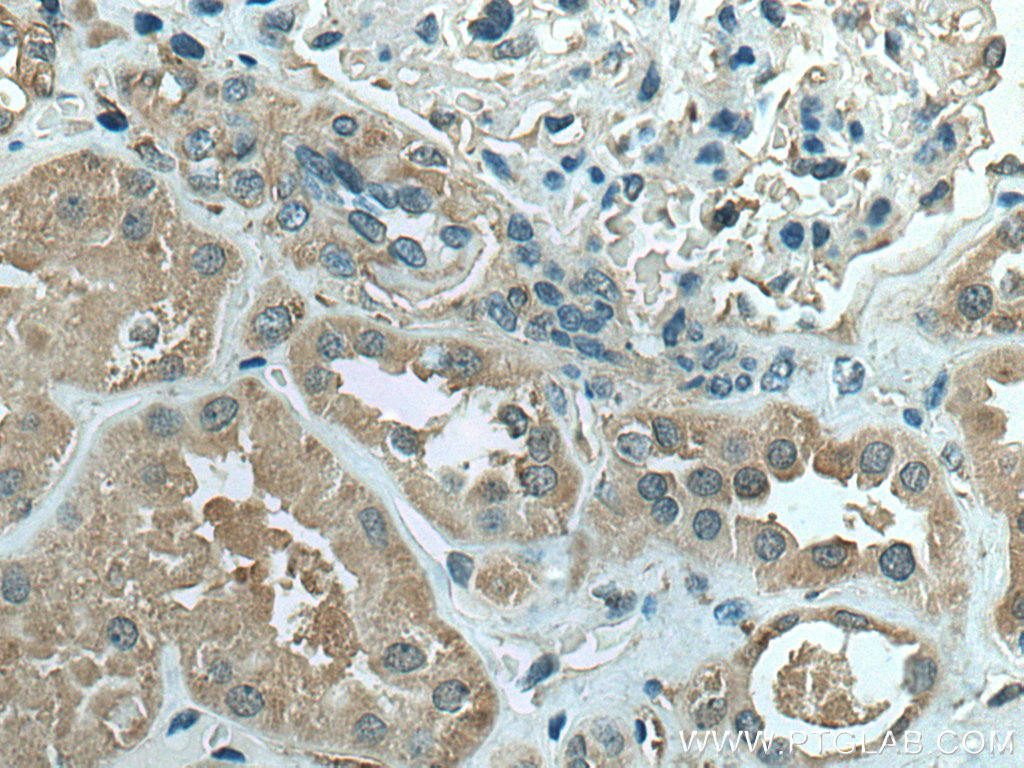

验证数据展示
经过测试的应用
| Positive WB detected in | MDA-MB-468 cells, HepG2 cells, THP-1 cells, Jurkat cells, Daudi cells, Raji cells, T-47D cells |
| Positive IHC detected in | human liver cancer tissue, human kidney tissue Note: suggested antigen retrieval with TE buffer pH 9.0; (*) Alternatively, antigen retrieval may be performed with citrate buffer pH 6.0 |
| Positive FC (Intra) detected in | Jurkat cells |
推荐稀释比
| 应用 | 推荐稀释比 |
|---|---|
| Western Blot (WB) | WB : 1:5000-1:50000 |
| Immunohistochemistry (IHC) | IHC : 1:250-1:1000 |
| Flow Cytometry (FC) (INTRA) | FC (INTRA) : 0.25 ug per 10^6 cells in a 100 µl suspension |
| It is recommended that this reagent should be titrated in each testing system to obtain optimal results. | |
| Sample-dependent, Check data in validation data gallery. | |
产品信息
66770-1-Ig targets IFIH1/MDA5 in WB, IHC, IF, FC (Intra), ELISA applications and shows reactivity with human samples.
| 经测试应用 | WB, IHC, FC (Intra), ELISA Application Description |
| 文献引用应用 | WB, IHC, IF |
| 经测试反应性 | human |
| 文献引用反应性 | human, mouse, pig, bovine |
| 免疫原 |
CatNo: Ag17448 Product name: Recombinant human IFIH1 protein Source: e coli.-derived, PET28a Tag: 6*His Domain: 1-310 aa of BC111750 Sequence: MSNGYSTDENFRYLISCFRARVKMYIQVEPVLDYLTFLPAEVKEQIQRTVATSGNMQAVELLLSTLEKGVWHLGWTREFVEALRRTGSPLAARYMNPELTDLPSPSFENAHDEYLQLLNLLQPTLVDKLLVRDVLDKCMEEELLTIEDRNRIAAAENNGNESGVRELLKRIVQKENWFSAFLNVLRQTGNNELVQELTGSDCSESNAEIENLSQVDGPQVEEQLLSTTVQPNLEKEVWGMENNSSESSFADSSVVSESDTSLAEGSVSCLDESLGHNSNMGSDSGTMGSDSDEENVAARASPEPELQLRP 种属同源性预测 |
| 宿主/亚型 | Mouse / IgG1 |
| 抗体类别 | Monoclonal |
| 产品类型 | Antibody |
| 全称 | interferon induced with helicase C domain 1 |
| 别名 | IFIH1, MDA5, 3D8B11, CADM-140 autoantigen, Clinically amyopathic dermatomyositis autoantigen 140 kDa |
| 计算分子量 | 1025 aa, 117 kDa |
| 观测分子量 | 117-125 kDa |
| GenBank蛋白编号 | BC111750 |
| 基因名称 | IFIH1 |
| Gene ID (NCBI) | 64135 |
| RRID | AB_2882116 |
| 偶联类型 | Unconjugated |
| 形式 | Liquid |
| 纯化方式 | Protein G purification |
| UNIPROT ID | Q9BYX4 |
| 储存缓冲液 | PBS with 0.02% sodium azide and 50% glycerol, pH 7.3. |
| 储存条件 | Store at -20°C. Stable for one year after shipment. Aliquoting is unnecessary for -20oC storage. |
背景介绍
IFIH1 (Interferon-induced helicase C domain-containing protein 1) is a putative RNA helicase that is upregulated in response to treatment with IFNB or IFNB and MEZ. It is also named as MDA5 and RH116. Ectopic expression of MDA5 in melanoma cells resulted in reduced colony formation, suggesting an interaction of the CARD and apoptotic signal molecules. Functional analysis indicated that MDA5 is an RNA-dependent ATPase. IFIH1 has an apparent molecular mass of 117-130 kDa, and always other bands (70 kDa and 90 kDa) can be detected as cleaved products (PMID: 17267501).
实验方案
| Product Specific Protocols | |
|---|---|
| FC protocol for IFIH1/MDA5 antibody 66770-1-Ig | Download protocol |
| IHC protocol for IFIH1/MDA5 antibody 66770-1-Ig | Download protocol |
| WB protocol for IFIH1/MDA5 antibody 66770-1-Ig | Download protocol |
| Standard Protocols | |
|---|---|
| Click here to view our Standard Protocols |
发表文章
| Species | Application | Title |
|---|---|---|
Adv Sci (Weinh) ADAR1 as a Placental Innate Immune Rheostat Sustaining the Homeostatic Balance of Intrinsic Interferon Response at the Maternal-Fetal Interface | ||
Virol Sin PRRSV degrades MDA5 via dual autophagy receptors P62 and CCT2 to evade antiviral innate immunity
| ||
J Virol Encephalomyocarditis virus abrogates the IFN-β signaling pathway via its structural protein VP2. | ||
Vet Microbiol DDX56 antagonizes IFN-β production to enhance EMCV replication by inhibiting IRF3 nuclear translocation | ||
Virus Res Host protein, HSP90β, antagonizes IFN-β signaling pathway and facilitates the proliferation of encephalomyocarditis virus in vitro. | ||
Front Immunol Temporally integrated transcriptome analysis reveals ASFV pathology and host response dynamics |